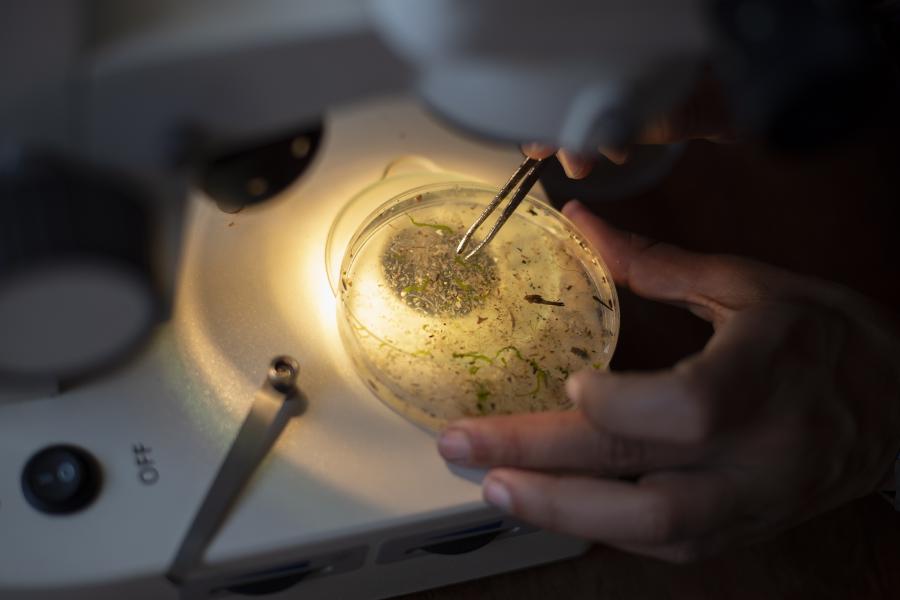
Lusa

Redação, 31 jan (Lusa) — Investigadores britânicos encontraram microplásticos em todos os mamíferos marinhos examinados num estudo com animais encontrados nas costas do Reino Unido, foi hoje anunciado.
Redação, 31 jan (Lusa) — Investigadores britânicos encontraram microplásticos em todos os mamíferos marinhos examinados num estudo com animais encontrados nas costas do Reino Unido, foi hoje anunciado.
Investigadores da Universidade de Exeter, sudoeste de Inglaterra, e do Laboratório Marinho de Plymouth (na mesma região) examinaram 50 animais, entre várias espécies de golfinhos, focas e baleias, e encontraram microplásticos (fragmentos com menos de cinco milímetros) em todos, segundo informação divulgada pela universidade.
A maior parte das partículas (84%) eram de fibras sintéticas, que podem vir de fontes como roupas, redes de pesca e escovas de dentes, enquanto as restantes provinham de fragmentos, possivelmente de embalagens de alimentos e garrafas de plástico.
“É chocante, mas não surpreendente, que todos os animais tenham ingerido microplásticos”, disse a principal autora do estudo, Sarah Nelms, da Universidade de Exeter e do Laboratório.
A investigadora disse que o número de partículas encontrado em cada animal foi em média de 5,5, “relativamente baixo”, o que sugere que as partículas ou passam pelo sistema digestivo ou são regurgitadas.
“Não sabemos ainda quais os efeitos que os microplásticos, ou os químicos neles presentes, têm nos mamíferos marinhos. É preciso mais investigação para se perceber melhor os possíveis impactos na saúde dos animais”, disse Sarah Nelms.
Segundo a investigação, foram várias as causas que provocaram a morte dos animais estudados, mas os que morreram devido a doenças infecciosas tinham mais partículas de plástico do que os que morreram por outras causas.
“Não podemos tirar nenhuma conclusão explícita sobre o potencial biológico desta observação”, notou Brendan Godley, do Centro de Ecologia e Conservação, da mesma universidade, concluindo que estão a ser dados “os primeiros passos na compreensão deste poluente omnipresente”.
Penélope Lindeque, do Laboratório de Plymouth, considerou “desconcertante” o facto de ter sido encontrado microplástico no intestino de todos os animais, observando que já tinham sido detetados microplásticos em quase todas as espécies de animais marinhos observados, desde os mais pequenos, na base da cadeia alimentar, até tartarugas.
“Ainda não sabemos os efeitos dessas partículas em mamíferos marinhos. O seu pequeno tamanho indica que podem ser facilmente expelidas. Mas embora os microplásticos possam não ser a principal ameaça ainda estamos preocupados com o impacto das bactérias, vírus e contaminantes transportados no plástico”, disse a responsável, salientando ser necessário reduzir a quantidade de resíduos de plástico lançados nos oceanos.
FP // JMR
Lusa/fim
